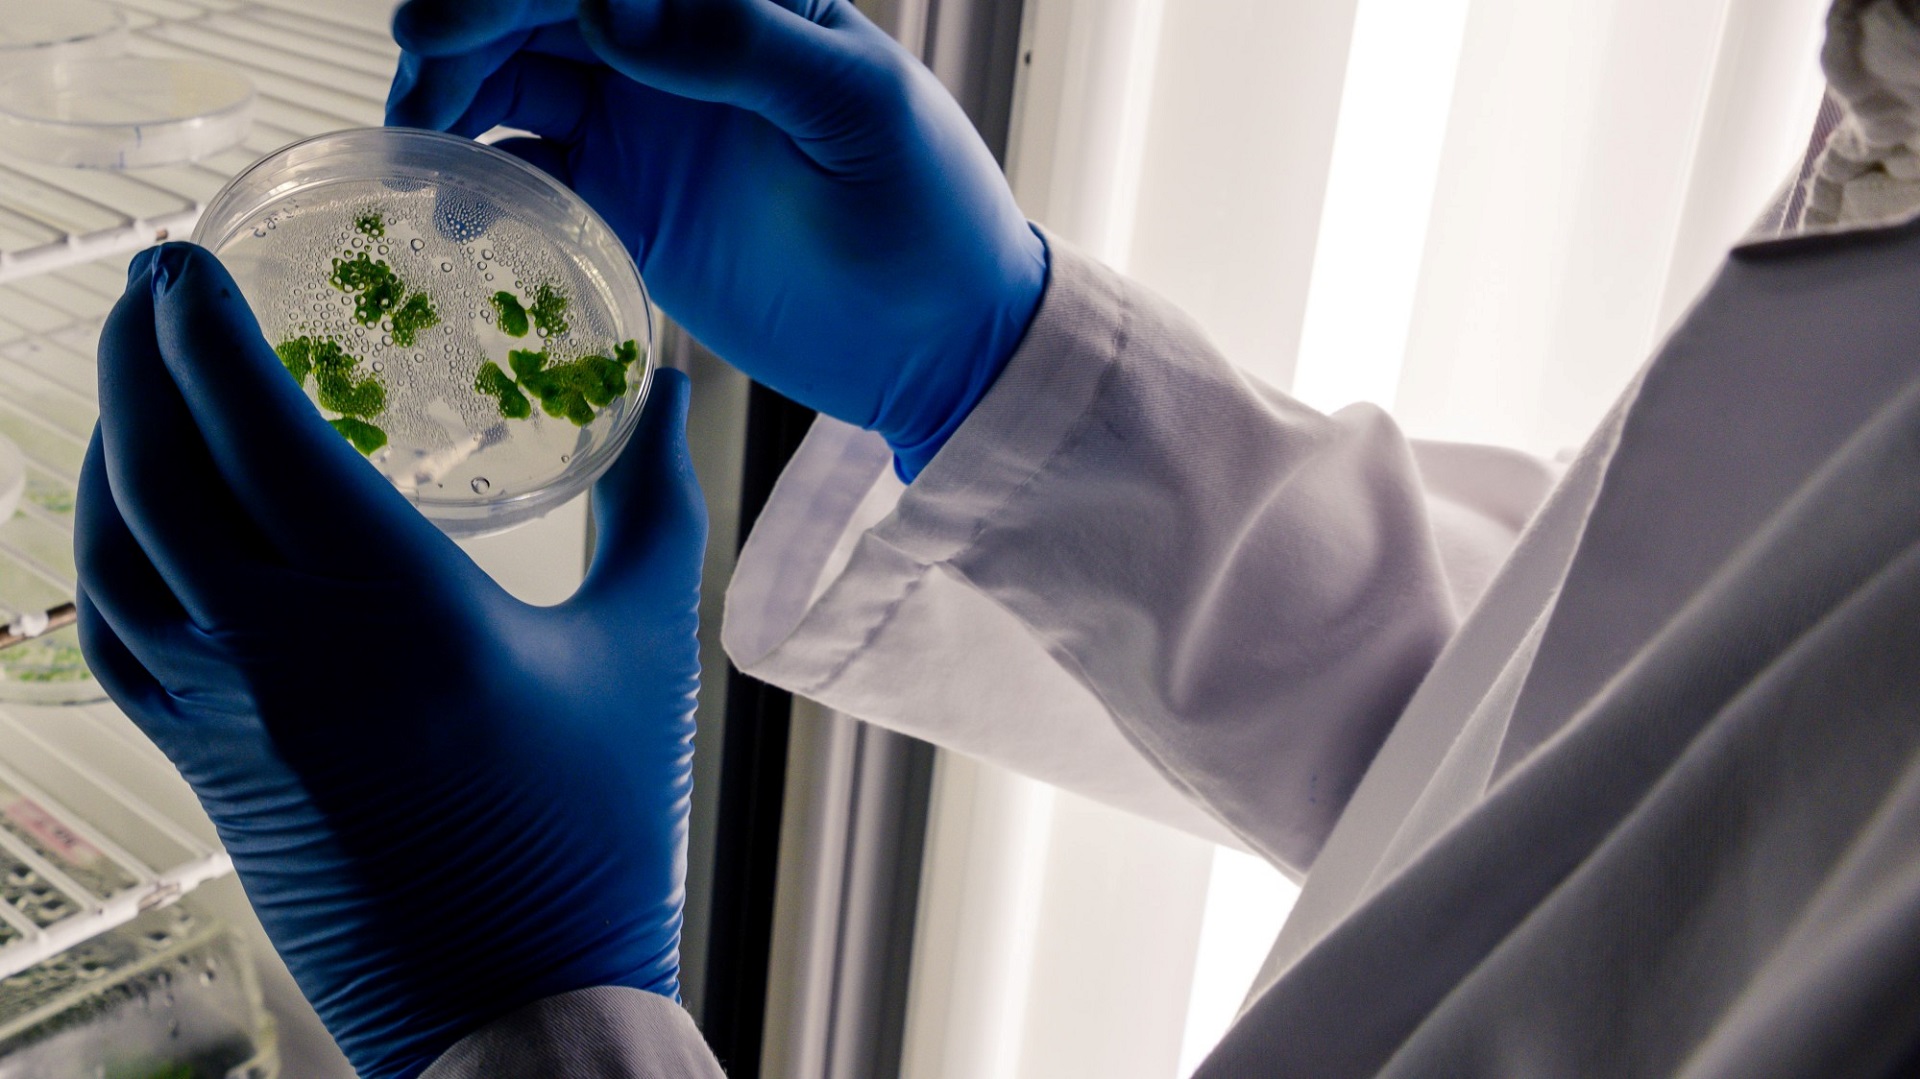
Vírus do Nilo Ocidental: O que sabemos sobre a transmissão ativa no Brasil?

O diagnóstico do primeiro caso de Febre do Nilo Ocidental, em fevereiro de 2026, no Mato Grosso, colocou os profissionais de saúde em estado de atenção, visto que se trata de ocorrência incomum. Assim, vale a pena revisarmos sobre a doença e como está sua transmissão no Brasil.
Estudo
Um estudo conduzido entre 2014 e 2024 apresenta a mais abrangente análise epidemiológica já realizada sobre a circulação do vírus do Nilo Ocidental (West Nile Virus – WNV) no Brasil, integrando dados nacionais e uma investigação longitudinal no estado do Ceará. Trata-se de um trabalho que combina vigilância epidemiológica, testes moleculares e sorológicos, análise filogenética e modelagem ecológica para caracterizar o padrão de transmissão viral no país.
Metodologia
Ao longo do período, foram notificados 110 casos humanos (prováveis ou confirmados) em 13 unidades federativas, demonstrando circulação contínua, embora em baixa magnitude. Destaca-se um pico em 2023, seguido de redução em 2024. A maior incidência foi observada no estado do Piauí, com predominância de detecção por sorologia IgM.
No Ceará, a investigação retrospectiva de 561 pacientes com febre aguda, doença neuroinvasiva ou óbito revelou soropositividade ou detecção molecular em 12,1% dos casos, com maior concentração entre 2022–2023. A apresentação clínica variou entre quadros febris autolimitados, neuroinvasivos e casos fatais. A circulação viral foi documentada ao longo de todo o ano, com maior frequência nos meses de novembro a março, período coincidente com maior pluviosidade e aumento da densidade vetorial.
AAP 2025: Novas vacinas, o que o pediatra precisa saber?
Resultados
A detecção de RNA viral ocorreu em 1,2% dos pacientes, especialmente em líquor, refletindo a conhecida baixa viremia e breve janela de detecção do WNV. A testagem concomitante excluiu coinfecções por DENV, CHIKV e ZIKV nesses casos. A soropositividade IgM, entretanto, apresentou alguma sobreposição com outros arbovírus endêmicos, embora a literatura indique menor taxa de reação cruzada para IgM quando comparada a IgG.
A análise filogenética demonstrou que o WNV identificados no Brasil pertence ao linhagem 1a, formando um clado único com origem provável na América do Norte. A introdução no território brasileiro é estimada em torno de 2007. O único genoma completo obtido no estudo originou-se de um equino com doença fatal no Ceará.
A modelagem ecológica apontou elevada adequação ambiental no Nordeste, especialmente no Ceará, seguida por áreas do Sudeste. Essa distribuição é coerente com a presença de vetores competentes, abundância de aves migratórias e condições climáticas favoráveis.
Considerações finais: Febre do Nilo Ocidental no Brasil
O estudo reforça que a ausência de grandes surtos na América do Sul não deve ser interpretada como ausência de risco. A circulação subdiagnosticada se soma a desafios como a semelhança clínica com outras arboviroses, limitações diagnósticas e heterogeneidade no esforço de vigilância entre as regiões brasileiras.
Conclui-se que o WNV circula de forma sustentada no Brasil, justificando o fortalecimento da vigilância, ampliação da capacidade diagnóstica — especialmente em casos neuroinvasivos — e inclusão do WNV como diagnóstico diferencial em meningites, encefalites e febres agudas de etiologia indeterminada, sobretudo em áreas coendêmicas para arboviroses.
Febre oropouche: Como estamos no Brasil?
Autoria

Raissa Moraes
Editora médica de Infectologia da Afya ⦁ Médica do Instituto Nacional de Infectologia Evandro Chagas/FIOCRUZ ⦁ Mestrado em Pesquisa Clínica pelo Instituto Nacional de Infectologia Evandro Chagas/FIOCRUZ ⦁ Infectologista pelo Instituto Nacional de Infectologia Evandro Chagas/FIOCRUZ ⦁ Graduação em Medicina pela Universidade Federal Fluminense
Como você avalia este conteúdo?
Sua opinião ajudará outros médicos a encontrar conteúdos mais relevantes.